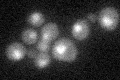
YBR194W
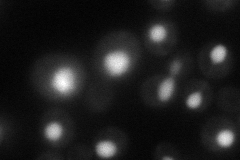
YBR194W
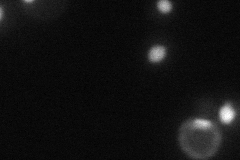
YBR194W

View description
Protein proposed to be associated with the nuclear pore complex; null mutant is viable, displays elevated frequency of mitochondrial genome loss and is sensitive to freeze-thaw stress
Localization:
Intensity:
Fold change:
Significance:
-
C’ GFP library in SD
nucleus21.27 -
N' NOP1pr-GFP in SD
nucleus60.825 -
N' TEF2pr-mCherry in SD
nucleus0 -
N' NATIVEpr-GFP in SD

nucleus27.3334 -
N' TEF2pr-VC and Cyto-VN in SD

#N/A0 -
C’ GFP library in SD+DTT

nucleus19.650.92No -
C’ GFP library in SD+H2O2

nucleus17.270.81Yes -
C’ GFP library in Starvation Media

nucleus19.360.9No -
C’ GFP library on the background of Pup2-DaMP

nucleus -
C’ GFP library on the background of CCT mutant

nucleus18.64820.876195No
